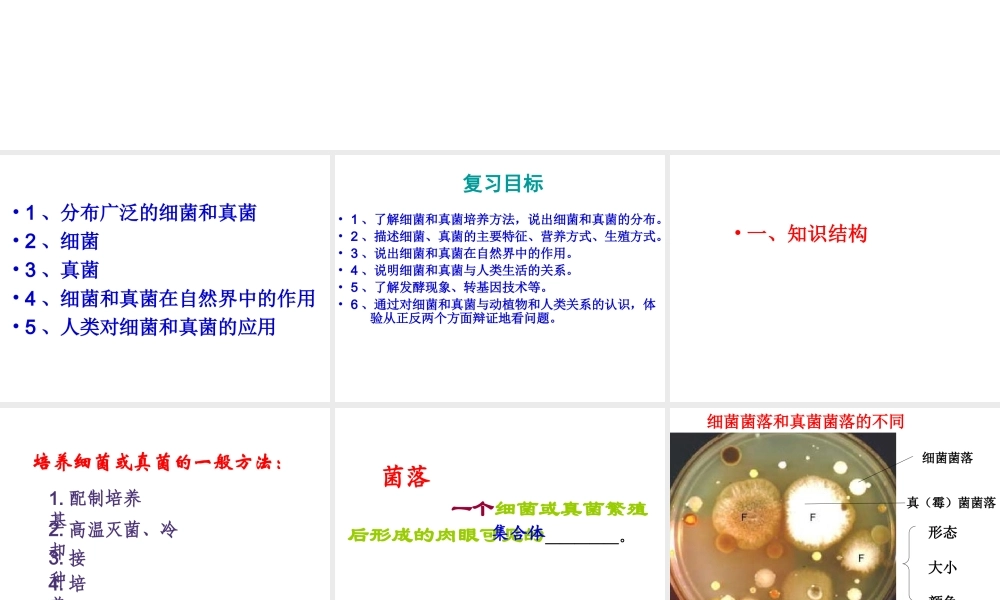
八年级生物上册 第四、五章 细菌真菌专题复习课件 人教新课标版

细菌和真菌(复习课)• 1 、分布广泛的细菌和真菌• 2 、细菌• 3 、真菌• 4 、细菌和真菌在自然界中的作用• 5 、人类对细菌和真菌的应用复习目标• 1 、了解细菌和真菌培养方法,说出细菌和真菌的分布
• 2 、描述细菌、真菌的主要特征、营养方式、生殖方式
• 3 、说出细菌和真菌在自然界中的作用
• 4 、说明细菌和真菌与人类生活的关系
• 5 、了解发酵现象、转基因技术等
• 6 、通过对细菌和真菌与动植物和人类关系的认识,体 验从正反两个方面辩证地看问题
• 一、知识结构培养细菌或真菌的一般方法:1
配制培养基2
高温灭菌、冷却3
形成菌落菌落 一个细菌或真菌繁殖后形成的肉眼可见的_____
集合体 细菌菌落真(霉)菌菌落形态大小颜色细菌菌落和真菌菌落的不同 比较 细菌菌落真菌菌落形态大小光滑粘稠 粗糙干燥绒毛状 絮状或蜘蛛网状小大细菌和真菌的分布细菌和真菌几乎无处不在,土壤、水中、空气、工农业产品、人体及动物、极端环境(寒冷的极地,热温泉中,深海的火山口发现古细菌)• 在生物圈中分布___
广泛细菌和真菌的生活必须具有的基本条件___、______、____
(有的还需要特殊条件有的需要氧气,有的必须没有氧气)水分适宜的温度有机物 细菌的发现者 列文•虎克1 、细菌不是自然发生的,而是由已存的细菌产生的
“ 微生物学之父”巴斯德2 、发现了乳酸菌、酵母菌3 、提出了巴氏消毒法____三种细菌球菌杆菌螺旋菌DNA 区细胞质细胞壁细胞膜荚膜(有些种类的细菌有)鞭毛(有些种类的细菌有)运动保护细菌的结构基本结构特殊结构特殊时期出现的结构芽孢:不是细菌的生殖细胞,而是在不良环 境下的休眠体
自养异养异养营养方式异养腐生寄生分裂生殖各种各样的真菌真菌大型真菌:蘑菇霉菌酵母菌多细胞种类单细胞种类:青霉曲霉相同点 1 :都是多细胞生物,每个细胞